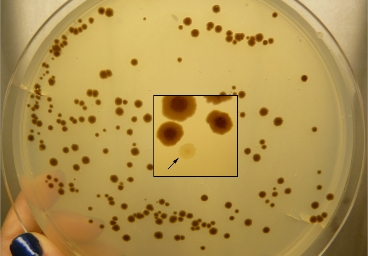
VAAM Mikrobe des Jahres 2019 VAAM Mikrobe des Jahres 2019

Magnetospirillum in Deutschland
(Institute/Arbeitsgruppen)
- Lehrstuhl für Mikrobiologie, Universität Bayreuth
- Abteilung Molekuare Ökologie am Max-Planck-Institut für Marine Mikrobiologie, Bremen

Mikrobiologie-Portale
- Kurzvideo "Die Zellhülle der Bakterien", Universität Tübingen
- Kurzvideo zur Bedeutung von Bakterien für unser Leben, Universität Tübingen
- Mikrobiologischer Garten
Jeder kennt zoologische oder botanische Gärten. Mikroorganismen nimmt man normalerweise kaum war, obwohl wir ständig von Milliarden von ihnen umgeben sind. Der Mikrobiologische Garten gibt Einblicke in die Welt der Mikroben anhand ausgewählter Geschichten, die sich hinter den Fenstern des Eingangsbildes verbergen. - Mikrobenzirkus
Blog über Wissenswertes und Kurioses aus Welt der Mikroben. - Micropia
Der Mikroben-Zoo in Amsterdam.
Audio
- SWR-Impuls, 12.8.2019: Magnetospirillum und seine magnetische Wirkung wollen Forscher etwa zur Tumorbekämpfung nutzen.
Literatur
- Magnetisch unterstützte Navigation in Bakterien I BIOspektrum 7/2025 I Daniel Pfeiffer, Bayreuth
- Maßgeschneiderte Mini-Magnete I Laborjournal 12/2023 I Larissa Tetsch
- Schlüsselprotein zur Zellform in Magnetbakterien entdeckt I Pressemitteilung zu Daniel Pfeiffer et al.I PNAS (2020). DOI: https://doi.org/10.1073/pnas.2014659117
-
Mit modernen Methoden zu magnetischen Mikroben I Rudi Amann, Dirk Schüler I Max-Planck-Institut für Marine Mikrobiologie Bremen und Lehrstuhl für Mikrobiologie, Universität Bayreuth I BIOspektrum 1/2019
-
Nanokristalle für die Magnetfeldorientierung: Die Biogenese von Magnetosomen in Bakterien I Dirk Schüler, René Uebe, Universität Bayreuth I BIOspektrum 1/2019
- Rätsel der Kompassnadel in Magnetospirillen gelöst I Pressemitteilung zu M. Toro-Nahuelpan et al I Nature Microbiology (2019). DOI: http://dx.doi.org/10.1038/s41564-019-0512-8.
- Magnetotaktische Bakterien steuern den Phosphatgehalt im Oberflächenwasser I Schulz-Vogt, H. N., et al. (2019): Effect of large magnetotactic bacteria with polyphosphate inclusions on the phosphate profile of the suboxic zone in the Black Sea I The ISME Journal online first I https://doi.org/10.1038/s41396-018-0315-6
- Warum so viele Organismen des Jahres gekürt werden I dpa 13.12.2018
- Bakterien mit Magnetsinn I Pressemitteilung MPI für Marine Mikrobiologie Bremen 2015
- Minikompass I Spektrum, November 2005
- Zellulärer Magnetsinn erfolgreich transplantiert I Pressemitteilung der LMU München 2014
- Insights into magnetic bacteria may guide research into medical nanorobots I Science in School - The European journal for science teachers I 51/2021
Video
- Bewegung magnetischer Bakterien: Magnetospirillum magneticum I igem-Team Washington 2011
- Kryo-Elektronentomographie von Magnetospirillum gryphiswaldense I Toro-Nahuelpan et al. 2016
Weitere Informationen:
- Fotos/Pressebilder (Urheberrechte beachten)
- Pressemitteilung Mikrobe des Jahres 2019
- Poster 2019
- ppt-Präsentation für Dozent*innen

